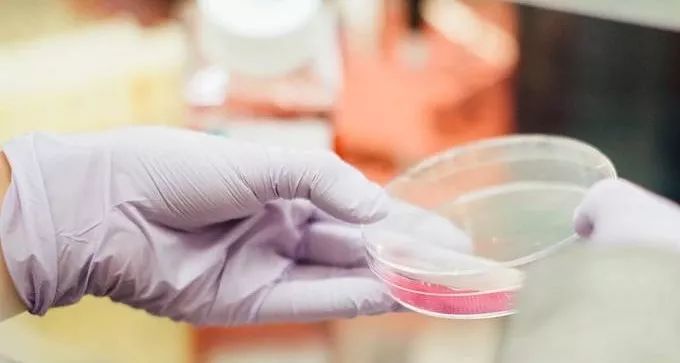
动物优质蛋白,小孩蛋氨酸过高

当今社会绝大多数人,甚至一些医学、营养学工作者,认为动物蛋白是优质蛋白,植物蛋白是劣质蛋白。
在上一篇文中,我们发现,仅摄入植物蛋白不会造成蛋白质缺乏,植物蛋白可以达到理想的蛋白质平衡。
今天,我们来比较,动物蛋白和植物蛋白在常见疾病中发挥的作用。
如果动物蛋白会促进癌症、骨质疏松、肾结石、肾衰、糖尿病,你还吃吗?
01 动物蛋白的蛋氨酸含量

动物蛋白的蛋氨酸比例高于植物性食物,有时甚至高出一倍[1]。
如果以蛋氨酸作为限制性氨基酸来计算,我们需要吃两倍的植物蛋白才能获得和动物蛋白等量的蛋氨酸。

这张图从高到低列出了食物中蛋氨酸的含量。我们发现,排在前面的都是动物性食物:
蛋类 、鱼类、肉类[2]。
今天,我们要重点讨论这个区别。

这是蛋氨酸参与的生化过程,涉及到 维生素B12 ,同型半胱氨酸、叶酸、维生素B6、DNA合成……等等。
蛋氨酸是蛋白质合成的起始氨基酸,人体必需氨基酸之一。在蛋白质合成过程中,第一个被加进蛋白质链的就是蛋氨酸。没有蛋氨酸,蛋白质合成不可能开始。
蛋氨酸和同型半胱氨酸之间可以相互转化。蛋氨酸转化为同型半胱氨酸时,会失去一个甲基,这个甲基被用于重要的细胞功能。比如,DNA合成需要胸腺嘧啶。而合成胸腺嘧啶所需的甲基就来源于蛋氨酸。

高浓度的同型半胱氨酸可促进动脉硬化,是心血管疾病的独立风险因素。
因此在满足DNA合成的需求之后,需要把同型半胱氨酸转化回蛋氨酸。这个转化过程需要叶酸,而维生素B12的作用是帮助叶酸的回收和再利用。
动物蛋白的摄入会提高血液蛋氨酸和同型半胱氨酸的浓度[3]。
02 蛋氨酸与寿命

不同动物心肌细胞的蛋氨酸含量有很大差别,心肌蛋氨酸含量,随动物的寿命增加而减少[4]。
之前的数据表明,限制热量摄入可以延长动物的生命。最近的研究发现,限制蛋氨酸可以达到类似的延长寿命的效果[5][6]。
因此采取植物性饮食,限制蛋氨酸,可能延长寿命。
03 蛋氨酸与癌症

科学家把癌细胞和普通细胞混在一起培养[7][8]。
在加入了蛋氨酸的培养基里,两个星期后,培养基里基本只剩下癌细胞。培养基里不放蛋氨酸,两个星期后,培养基里癌细胞已死亡,正常细胞仍在生长。
理论上,两种细胞都没办法在缺乏蛋氨酸的环境里生存,因为蛋氨酸是必需氨基酸。
研究者在无蛋氨酸的培养基里加了叶酸、维生素B12和同型半胱氨酸,于是正常细胞就能转化出蛋氨酸。癌细胞在癌变的过程中丢失了这个转化机制,在缺乏蛋氨酸的环境里,即使有同型半胱氨酸,也无法存活。
植物蛋白的蛋氨酸含量低实际是优势,可以帮助抑制癌细胞。

研究者把乳腺癌细胞分别放在无药、含有化疗药Dox、含有靶向抗体药Lexa的培养基中,再在培养基中提供或者不提供蛋氨酸,然后观察药物效果[9]。
结果发现,蛋氨酸缺乏的培养基,抑制癌细胞的效果甚至比单纯用化疗药Dox还要好,和靶向抗体药Lexa接近。如果限制蛋氨酸与靶向抗体药Lexa结合,几乎可以彻底清除癌细胞!
由此可见,限制蛋氨酸不仅可以抑制癌细胞,还可以加强其它治疗方法的效果。

可以预测,乳腺癌患者在接受靶向抗体药Lexa治疗时,采取植物性饮食,降低蛋氨酸摄入,治疗效果比动物性饮食好得多。
在已发表的临床案例中,限制蛋氨酸,人体癌细胞指标有不同程度的改善[10][11]。
用低蛋氨酸的植物性饮食取代高蛋氨酸的动物性饮食,有利于抗癌。
04 动物蛋白与癌症

除了低蛋氨酸抗癌以外,植物蛋白不同于动物蛋白的综合氨基酸配比,可能通过影响
生长因子IGF-1 的水平,降低肿瘤的风险[12]。
注:IGF-1(类胰岛素生长因子-1),是一种促进细胞生长的因子,无论是癌细胞还是正常细胞的生长都能促进。平时,大部分IGF-1和IGF-1结合蛋白在一起,IGF-1处于被抑制状态。当身体需要时,IGF-1和IGF结合蛋白分开,变成有生物活性的生长因子。IGF-1和IGF-1结合蛋白的关系,就好比灭火器和安全阀。如果安全阀比灭火器少,有些灭火器就会没有安全阀,增加误喷几率。
一项研究发现,比起吃动物蛋白的人,不吃任何动物蛋白的人,IGF-1的水平低13%,IGF-1结合蛋白的水平反而高出20%-30%[12]。

纯素食者与非素食者比,有较少的灭火器和更多的安全阀。纯素食者体内的生长因子IGF-1更安全,非素食者体内的灭火器(生长因子IGF-1)发生误喷的几率比较大。
不吃肉但吃蛋奶的人,体内IGF-1和IGF-1结合蛋白的水平与其他非素食者没有区别[12]。
在美国的AHS研究中,蛋奶素的人患癌症的几率接近于非素食者,远高于纯素食人群[13]。
吃素就吃纯素,蛋奶素因为仍然在摄入动物蛋白,没什么优势。
05 动物蛋白与骨质疏松
蛋氨酸是含硫氨基酸,在代谢中会产生硫酸根,导致不健康的酸性代谢微环境(酸中毒)。研究发现,摄入动物蛋白,会降低尿液pH (提高尿液酸度)[14]。

酸性尿液排出,会导致钙离子的流失[15]。研究发现,摄入动物蛋白,尿液的钙浓度随之增加[16]。
钙离子流失升高骨质疏松的风险。一项涉及33个国家的相关性调查表明,膳食中植物蛋白/动物蛋白的比例越高,髋骨骨折发生率越低[17]。

证据更强的前瞻性研究结果,进一步解释了以上临床和生态学数据[18]。
科学家对不同动植物蛋白比例的受试者做了8年跟踪,每年记录尚未发生骨折的人数。结果动物蛋白摄入比例最高的那组,未发生骨折的人数减少得最快。这说明摄入动物蛋白,更容易诱发骨折。

06 动物蛋白与肾结石
动物蛋白导致代谢酸中毒。
为保持体内酸碱平衡,作为代偿措施,肾脏会优先排出不能代谢的阴离子-如硫酸根,保留可代谢的阴离子-如柠檬酸根,同时增加产氨,排出氨离子[19]。
这些补偿反应导致尿pH降低 (酸度增加),柠檬酸排出减少,以及钙、氮、磷的流失[15]。

尿液酸度增加,会提高尿酸结石的风险。研究发现,碱性的植物性饮食有利于抑制尿酸在体内结晶(痛风),以及尿酸的排出[20]。
低柠檬酸和高尿钙,会增加钙结石的风险。哈佛大学对于医护人员的三项研究,接近20万受试者,发现随着动物蛋白摄入的升高,以及来自于植物的钾离子摄入降低,肾结石的风险升高[21]。

另一项研究发现,不同来源的动物蛋白都可以增加肾结石的风险。
因此,研究者建议肾结石患者应该避免所有动物蛋白[22]。
07 动物蛋白与肾病
动物蛋白代谢产生的酸性微环境,不光导致钙流失,诱发骨质疏松和肾结石,在酸排出时,
对于肾脏有很大的伤害[23]。当肾功能减弱,酸潴留恶化,进入恶性循环。
现在很多肾病病人被建议食用动物蛋白,避免植物蛋白。但研究数据证明,纯植物性饮食不但对肾病患者没有副作用[24],相反可显著降低患者的血磷水平(高磷是不好的信号)[25]。

慢性肾病患者植物蛋白摄入百分比越高,慢性肾病死亡风险越低[26]。
植物才是肾病患者的首选蛋白质来源。
08 动物蛋白与糖尿病
动物蛋白导致的代谢酸中毒,通过多种可能的机制[27],促进胰岛素抵抗[28],增加2型糖尿病的风险。
哈佛大学对于医护人员的研究还发现,动物蛋白导致的膳食酸负荷与2型糖尿病有剂量效应关系[29]。
收纳10个研究队列,50万人的 荟萃分析 发现,动物蛋白显著增加2型糖尿病的风险;而植物蛋白倾向于降低二型糖尿病的风险[30]。

小结
- 动物蛋白因为它各类氨基酸的比例,更容易诱发癌症、骨质疏松、肾结石、肾病、糖尿病等疾病。
- 动物蛋白中的蛋氨酸比植物蛋白高出近一倍,很多食用动物蛋白产生的问题,实际是蛋氨酸过多的问题。

蛋白质的优劣,不应光看它提供什么营养,更要看它带来什么害处。
关键不是吃什么,而是不 吃什么。
植物蛋白完全可以满足营养需求 ,避免有健康风险的动物蛋白已经日益成为现代人有智慧的选择。

参考文献:
[1] Nutr Metab Cardiovasc Dis. 2011 Sep;21 Suppl 2:B16-31.
[2] J Nutr. 1994 Oct;124(10):1934-41.
[3] http://nutritiondata.self.com/foods-000084000000000000000-1.html?
[4] Med Hypotheses. 2009 Feb;72(2):125-8
[5] Methods Mol Biol. 2019;1866:263-266.
[6] http://www.benbest.com/calories/Meth.html
[71] In Vitro. 1975 Jan-Feb;11(1):14-9
[8] Proc Natl Acad Sci U S A. 1974 Apr;71(4):1133-6
[9] Clin Cancer Res. 2015 Jun 15;21(12):2780-91
[10] J Am Coll Nutr. 2001 Oct;20(5 Suppl):443S-449S;
[11] Nutr Cancer. 2002;42(2):158-66.
[12] Cancer Epidemiol Biomarkers Prev 2002;11:1441-1448.
[13] Am J Clin Nutr. 2014 Jul;100 Suppl 1:353S-8S
[14] J Ren Nutr. 2008 Sep;18(5):456-65.
[15] N Engl J Med. 1979 Sep 6;301(10):535-41
[16] Br J Urol. 1979; 51(6):427-31.
[17] J Bone Miner Res. 2016 Feb;31(2):326-35.
[18] Am J Clin Nutr. 2001 Jan;73(1):118-22.
[19] Clin Nutr. 2011 Aug;30(4):416-21
[20] Nutr J. 2012 Jun 7;11:39.
[21] Clin J Am Soc Nephrol. 2016 Oct 7;11(10):1834-1844.
[22] J Urol. 2014 Jul;192(1):137-41.
[23] Tohoku J Exp Med. 1989 Oct;159(2):153-62.
[24] J Ren Nutr. 2019 Mar;29(2):112-117.
[25] Clin J Am Soc Nephrol. 2011 Feb;6(2):257-64
[26] Am J Kidney Dis. 2016 Mar;67(3):423-30
[27] Biochimie. 2016 May;124:171-177
[28] Clin Nutr. 2016 Oct;35(5):1084-90.
[29] Diabetologia. 2017 Feb;60(2):270-279
[30] Am J Clin Nutr. 2016Nov;104(5):1352-1365
延伸阅读:
求你别再说吃素缺蛋白质了,小心过剩!
从“酸性体质”事件我们能学到什么?
关于鸡蛋,我们是如何陷入误区的?
维生素B12答疑汇总|粪便中富含的营养素
癌细胞最喜欢这种氨基酸
慢性肾脏病患者的膳食建议
欢迎关注:头条号【嘉讲健康】
获得最新最前沿的健康营养学知识,低脂全蔬食恢复身体自愈力,吃出健康。
徐嘉
《非药而愈》作者
责任医师协会临床营养学专家
约翰霍普金斯大学医学院生理学博士
北京大学生物物理学士
公益健康巡讲
2014年至今健康公益巡讲的足迹,遍步全国30多个省级区域,100多座城市。200多个承办单位参与,共举办940余场公益讲座,10余万名听众现场聆听,影响数百万人。

作者介绍导图:Ariel Han